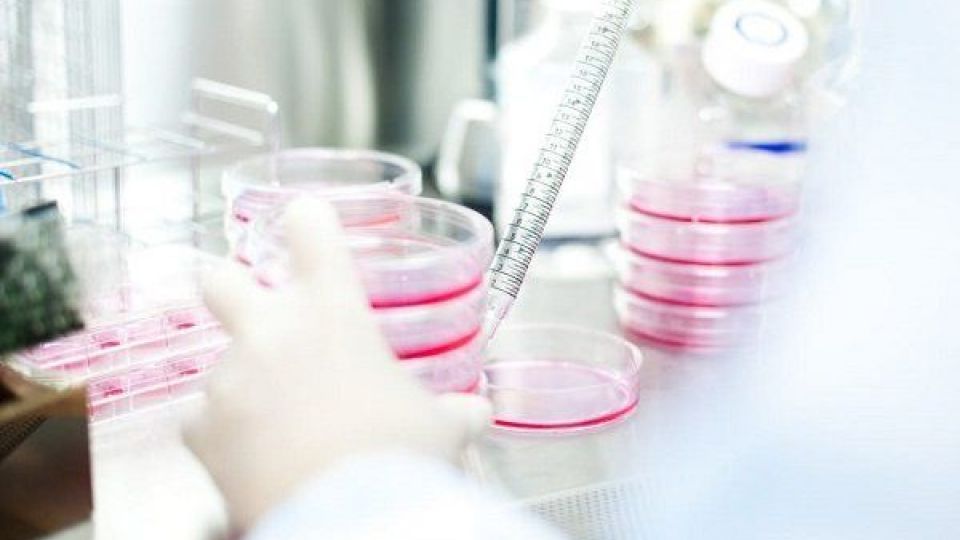

دکتر امیرعلی حمیدیه در گفتگو با مهر با تاکید بر اینکه روز به روز شاهد افزایش تعداد شرکتهای دانش بنیان، هستههای فناور، شتابدهنده ها و… در زمینه سلولهای بنیادی کشور هستیم، گفت: در حال حاضر بیش از ۱۶۰ شرکت در حوزه سلول بنیادی فعالیت میکنند که از این تعداد ۱۳۰ شرکت دانش بنیان شده است.
دبیر ستاد توسعه سلول بنیادی با بیان اینکه ما به دنبال این هستیم که شرکتها به سمت تولید محصولاتی بروند که مورد نیاز کشور است، گفت: در حال حاضر هم علاوه بر نیاز جامعه شاهد مطالبه مردم در حوزه ژن درمانی، سلول درمانی و طب بازساختی هستیم از این رو میبایست تولید محصولات در این حوزهها افزایش یابد.
به گفته حمیدیه، سلول بنیادی و اقدامات مربوط به سلول متأثر از تحریمها نیست و شرکتهای فنی و مهندسی خودشان را تقویت کرده اند که بتوانند محصولات مورد نیاز کشور را برای تحقیقات و مصرف به تولید برسانند.
وی با تاکید بر اینکه اما جدای از تولید تجهیزات که توسط شرکتهای دانش بنیان به تولید میرسد و ستاد توسعه سلول بنیادی هم از آنها حمایت میکند، ایجاد مراکز جامع سلول بنیادی و پزشکی بازساختی نیز مهم است، ادامه داد: تاکنون در بسیاری از دانشگاههای علوم پزشکی کشور، مرکز جامع سلول بنیادی و پزشکی بازساختی راه اندازی شده که میتوان به دانشگاههای علوم پزشکی تبریز، شیراز، تهران، کرمانشاه، مشهد، کرمان، یزد، ایران و پژوهشگاه رویان اشاره کرد.
دبیر ستاد توسعه سلول بنیادی با اشاره به برنامه ریزی ها برای ایجاد مراکز جامع سلول بنیادی گفت: بنا داریم که تا دو ماه آینده مرکز جامع سلول بنیادی در دانشگاه تربیت مدرس و بعد از آن در دانشگاه صنعتی شریف را راه اندازی کنیم.
وی با بیان اینکه در حال حاضر تیمها در این مراکز مستقر شده اند یا در حال استقرار و انجام مطالعات در زمینه سلول بنیادی و اقدامات برای تولید محصولات در این زمینه هستند، گفت: تیمها و هستههای فناور در این مراکز محصولاتی را تولید میکنند که بنا داریم همزمان با افتتاح مراکزشان از محصولاتشان نیز رونمایی کنیم.
حمیدیه با بیان اینکه برخی محصولاتی که در این حوزه به تولید می رسند در انحصار آمریکا، آلمان و چند کشور دیگر است، گفت: بعضی از این تجهیزات توسط همین دانش بنیانها در حال تولید است یا تولید شده و در حال استفاده هستند بنابراین دیگر نیازی به واردات آنها نداریم.
دبیر ستاد توسعه فناوری سلول بنیادی ادامه داد: تمام چرخه صنعتی حوزه سلول بنیادی را خودمان تولید میکنیم و امیدواریم که تا ۲-۳ سال دیگر صاحب صنعت در حوزه سلول بنیادی شویم؛ سلول بنیادی مانند صنایع دیگر در حوزه مواد اولیه یا تجهیزات وابسته به خارج از کشور نیست و صنعتی کاملاً داخلی محسوب میشود.